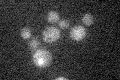
YOR368W

View description
Checkpoint protein, involved in the activation of the DNA damage and meiotic pachytene checkpoints; with Mec3p and Ddc1p, forms a clamp that is loaded onto partial duplex DNA; homolog of human and S. pombe Rad1 and U. maydis Rec1 proteins
Localization:
Intensity:
Fold change:
Significance:
-
C’ GFP library in SD

below threshold16.03 -
N' NOP1pr-GFP in SD

nucleus55.4929 -
N' TEF2pr-mCherry in SD

nucleus43.0287 -
N' NATIVEpr-GFP in SD

punctate,nucleus21.9854 -
N' TEF2pr-VC and Cyto-VN in SD

#N/A0 -
C’ GFP library in SD+DTT

cytosol16.081No -
C’ GFP library in SD+H2O2

cytosol17.151.06No -
C’ GFP library in Starvation Media
cytosol15.140.94No -
C’ GFP library on the background of Pup2-DaMP

below threshold -
C’ GFP library on the background of CCT mutant

below threshold17.12841.06802No
